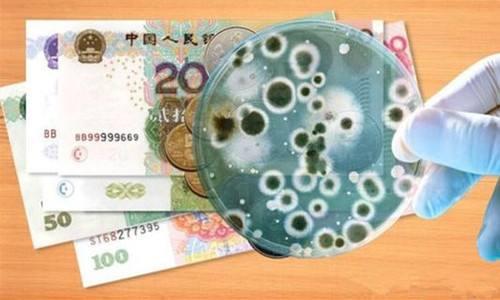

纸币平均携带178000个细菌就算了,为什么南方纸币携带的细菌比北方要多?
纸币平均携带178000个细菌就算了,为什么南方纸币携带的细菌比北方要多?
-
谢谢邀请。南方天气暖和,尤其广州四季如春,人流量大。大小便后洗手,吃饭前洗手,可没见过数钱时洗手。洗钱倒是听过,但此洗钱不是彼洗钱。所以钱上有那么多细菌不奇怪。
2017-04-24 10:47:38 -
谢谢邀请作答;源于环境差异所致。温暖潮湿的南方有利于细菌的存活和繁殖,对比寒冷干燥的北方,肉类等有机物更容易腐烂,就是直观例证。
2017-04-24 11:13:10 -

北方空气干燥、寒冷。南方易雨、潮湿细菌容易滋生。
 2017-04-24 12:27:39
2017-04-24 12:27:39 -
南方与北方差别主要方面是气候关系。北方气候干燥,南方多雨潮湿,细菌繁殖比北方快,为什么?南方温度适宜,人员流向较大,商业网络较多,纸币流动性较强,所以携带纸币不管直接,间接数量巨大,细菌传播又快,量大,这是主要原因,气候适宜,更加速了细菌繁殖,所以,南方纸币比北方纸币细菌传播快,多,气候,温度,人员流动大是主要原因。
2017-04-24 16:48:29 -
平均每张纸币含菌量17.8万个?南方常年高温湿热,纸币携菌量比北方更多?日前,包括联合国环境署、广州妇女儿童医疗中心等15家国内外机构公布的研究数据让人意外。医学专家表示,纸币确实携带菌类,但细菌有好有坏,只要勤洗手讲卫生,无须“谈菌色变”。
每张纸币含菌量17.8万个
最近,由联合国环境署、支付宝、广州妇女儿童医疗中心等15家国内外机构组成的无现金联盟成立,其公布了香港城市大学此前研究中国内地货币的检测结果,显示每张纸币平均含菌量17.8万个,5角、1元、1角面额的纸币,每张附带的菌数更高达1800万个。研究显示,钱币的带菌数与地区气候有一定的关系,因为气候在一定程度上影响着细菌的生存条件。广州和重庆的纸币要比北京更多菌,这与广州、重庆地处南方常年高温湿热,而北京较干燥寒冷有关。检测结果显示,由于反复使用,多数钱币都会受到细菌污染,大肠杆菌、金黄色葡萄球菌、绿脓杆菌、沙门氏菌是钱币上最常见的细菌。
2017-04-24 10:18:59
2017-04-24 10:18:59 -
平均每张纸币含菌量17.8万个?南方常年高温湿热,纸币携菌量比北方更多?日前,包括联合国环境署、广州妇女儿童医疗中心等15家国内外机构公布的研究数据让人意外。医学专家表示,纸币确实携带菌类,但细菌有好有坏,只要勤洗手讲卫生,无须“谈菌色变”。
每张纸币含菌量17.8万个
最近,由联合国环境署、支付宝、广州妇女儿童医疗中心等15家国内外机构组成的无现金联盟成立,其公布了香港城市大学此前研究中国内地货币的检测结果,显示每张纸币平均含菌量17.8万个,5角、1元、1角面额的纸币,每张附带的菌数更高达1800万个。研究显示,钱币的带菌数与地区气候有一定的关系,因为气候在一定程度上影响着细菌的生存条件。广州和重庆的纸币要比北京更多菌,这与广州、重庆地处南方常年高温湿热,而北京较干燥寒冷有关。检测结果显示,由于反复使用,多数钱币都会受到细菌污染,大肠杆菌、金黄色葡萄球菌、绿脓杆菌、沙门氏菌是钱币上最常见的细菌。
2017-04-24 10:18:59 -
因为南方空气湿度大,雨热同期,每年有近三个月的时间都在蒸桑拿,这就为细菌的滋生创造了良好的条件。
2017-04-23 22:13:05
